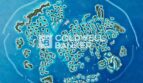
image

Coldwell Banker Swap is delighted to offer an exceptional private island within the iconic World Islands, one of Dubai’s most visionary and prestigious developments.
These freehold islands offer remarkable potential for discerning investors and developers to create ultra-luxury resorts, private sanctuaries, or signature villa communities set in a truly one-of-a-kind destination just minutes from Dubai’s mainland.
Island Highlights
Land Area: 471,221.82 Sq. Ft
Ownership: Freehold
Images are for illustrative purposes only.
Developed by Nakheel, The World Islands is a remarkable collection of 300 man-made islands designed to mirror the world map, located just 4 km off the coast of Dubai. This iconic destination offers exceptional privacy, exclusivity, and creative freedom, making it a truly unique address for luxury living, hospitality, and visionary investment unlike anywhere else in the world.
About Coldwell Banker Swap:
Coldwell Banker Swap Branch is one of the UAE franchises of the American Real Estate brand Coldwell Banker, offers a variety of services ranging from seller/owner services, and property management services to concierge services, as well as providing sales and marketing solutions to developers. With over 3600 offices and 126,000 Sales Associates worldwide, Coldwell Banker secures its title as one of the largest global real estate organizations. Swap Real Estate is guided by Coldwell Banker’s commitment to professionalism and customer service, which remains the core of its business philosophy.
- Category
- Buy
- 471,221 ft2